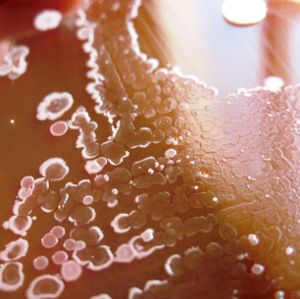

Portail Biotech
Photo : © Catherine BARDIAUX, pour UPBM.
Vous avez dit "Biotechnologies" ?
Génie biologique, biotechnologies, biotechno, biotech, bio appliquée... pas mal de noms pour une discipline pas toujours simple à définir - et c'est normal ! Car en réalité les biotechnologies regroupent de très nombreux domaines assez distincts - leur point commun ? De la biologie, donc, appliquée à un champ professionnel précis : santé, écologie et environnement, agroalimentaire, génie des procédés, etc. Retrouvez ci-dessous :
- une présentation rapide des principaux secteurs professionnels offrant des débouchés très variés à nos élèves,
- une présentation simplifiée des enseignements assurés par les professeurs de Biotechnologie (dits aussi professeurs de biochimie-génie biologique), dans nos sections,
- quelques métiers caractéristiques (mais non exhaustifs !) auxquels nos formations permettent d'accéder.

Des enseignements variés, mais toujours appliqués au réel.
Photo : (c) Antoine GAUDIN.
Les enseignements de biotechnologies sont extrêmement variés car ils correspondent à des sous-domaines très spécialisés de la biologie de pointe. Dans l'enseignement supérieur, ils correspondent à des débouchés très distincts : diagnostic, contrôle, recherche, etc., en santé, environnement, alimentaire, pharmaceutique, etc.
En conséquence, les enseignants sont formés et forment à des techniques et connaissances de pointe, toujours appliquées à un objet réel et concret. Les compétences qu'on acquiert dans les formations biotechnlogiques sont des compétence bien sûr biotechnologiques mais aussi transversales très utiles et recherchées dans la vie professionnelle et sociale de tous les jours. Les laboratoires où ont lieu les enseignements sont des laboratoires modernes adaptées aux exigences de rigueur et de sécurité de la science du XXIème siècle.
En savoir plus :
Des secteurs d'activité
tournés vers l'avenir
Les débouchés professionnels vers lesquels les formations biotechnlogiques conduisent sont tous liés à des secteurs touchant aux questions brûlantes de notre société et du XXIième siècle (cliquez sur les images pour en savoir plus).


Des métiers variés
mais tous passionnants
Les débouchés professionnels vers lesquels les formations biotechnlogiques conduisent sont tous liés à des secteurs touchant aux questions brûlantes de notre société et du XXIième siècle (cliquez sur les images pour en savoir plus).